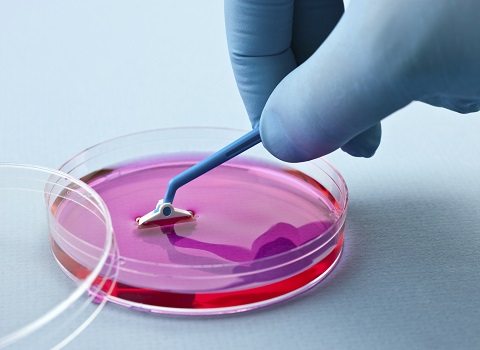

تلویزیونهای قدیمی دارای جاذبه ویژهای برای علاقهمندان به فنون قدیمی هستند که با افزایش تقاضا برای این انواع تلویزیونها، قیمت جیوه به عنوان یکی از اجزای اصلی تعیین کننده قیمت آنها در بورس همچنان تحت تأثیر قرار میگیرد.

روند قیمت جیوه در بازار تلویزیون قدیمی
تعریف قیمت جیوه در ایران و کاربردها در تلویزیونهای قدیمی،تحلیل روند قیمت جیوه در طی سالهای گذشته، تأثیر علل و عوامل مختلف بر روند قیمت جیوه.
عوامل مؤثر بر قیمت جیوه در تلویزیون قدیمی
تأثیر عرضه و تقاضا بر قیمت جیوه، تأثیر تغییرات فنی و فناوری بر قیمت جیوه وتأثیر تعدیلات قانونی و مقررات دولتی بر قیمت جیوه.
استفاده از مدلهای ریاضی و روشهای تحلیلی برای پیشبینی قیمت جیوه، ارزیابی تأثیر عوامل مؤثر بر آینده قیمت و جیوه در بازار تلویزیون قدیمی.
نتیجهگیری:
قیمت جیوه به عنوان یک نشانگر اصلی در تعیین قیمت تلویزیونهای قدیمی تأثیر قابل توجهی دارد و تحلیل دقیق و پیشبینی قیمت جیوه میتواند به تولیدکنندگان، عرضهکنندگان و خریداران کمک کند تا تصمیمات اقتصادی مناسبتری بگیرند و ریسکها را کاهش دهند.

بخش تکمیلی:
اگر میخواهید مقاله خود را بهبود ببخشید، توصیه میکنم به موارد زیر توجه کنید:
محصول - درباره تلویزیونهای قدیمی بیشتر بحث کنید، ویژگیها، نوعیت تکنولوژی و ارزش آنها را توضیح دهید و همچنین در زمینه تولید و فروش آنها، جایگاه قیمت جیوه را نیز بررسی کنید.
تحلیل بازار - بازار تلویزیون قدیمی را در نظر بگیرید و عواملی که قیمت آنها را تحت تأثیر قرار میدهند شناسایی کنیدواین عوامل میتوانند عرضه و تقاضا، تغییرات فنی و فناوری، تعدیلات قانونی و مقررات دولتی و سایر عوامل باشند.
پیشبینی - از مدلهای ریاضی و روشهای تحلیلی برای پیشبینی قیمت جیوه استفاده کنید و همچنین بررسی کنید که چگونه تأثیر عوامل مشترک در آینده قیمت جیوه قرار میگیرند علاوه بر این نیاز است تا ریسکهای مرتبط با پیشبینیهای قیمت جیوه را نیز بررسی کنید.

نتیجهگیری و توصیهها - تأثیر قیمت جیوه در بازار تلویزیون قدیمی و نقش آن در تحلیل و پیشبینی قیمت تلویزیونها را بررسی و موضوع را به یک نکته پایانی برسانیدهمچنین توصیههایی برای تولیدکنندگان، عرضهکنندگان و خریداران درباره تصمیمات اقتصادی و کاهش ریسکها ارائه دهید.
تنظیم و ارائه - جملات و پاراگرافها را با دقت تنظیم و به نحوی که ایدهها و مفاهیم به خوبی منتقل شوند، بنویسیدو همچنین، به دقت املایی و گرامری توجه کنید و متن را به صورت کامل و جامع ارائه دهید.
استفاده از این موارد، شما را در تهیه یک مقاله تجاری قوی و کامل درباره قیمت جیوه در تلویزیون قدیمی کمک خواهد کردو با توجه به تجربه شما به عنوان یک نویسنده حرفهای، مطمئناً میتوانید یک مقاله با کیفیت و جذاب ایجاد کنید.